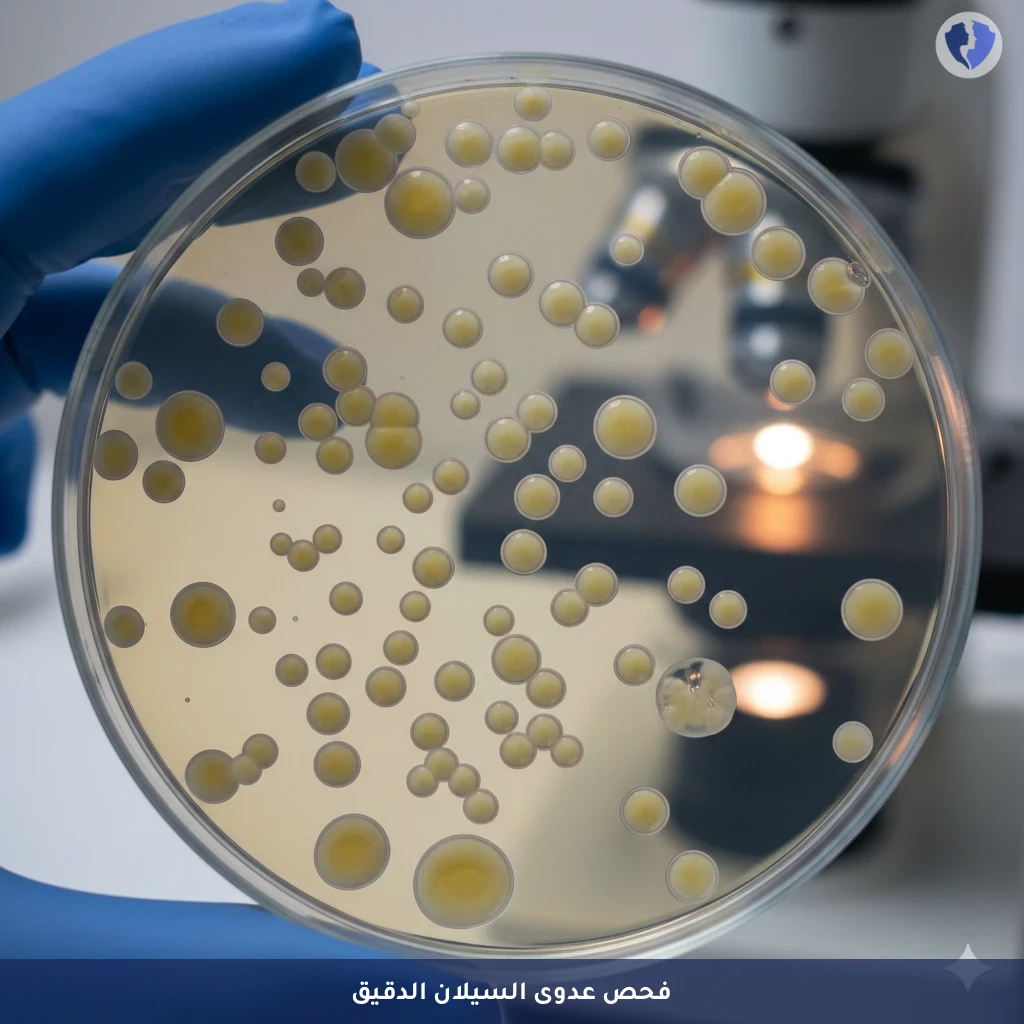
فحص مزرعة بكتيريا السيلان - مزرعة بكتيريا النيسرية البنية (Neisseria Gonorrhoeae)

تفاصيل الخدمة
فحص مزرعة بكتيريا السيلان - مزرعة بكتيريا النيسرية البنية (Neisseria Gonorrhoeae)
فحص ميكروبيولوجي يعتبر المعيار الذهبي لتشخيص عدوى النيسرية البنية (Neisseria gonorrhoeae)، البكتيريا المسببة لمرض السيلان. يتم تلقيح العينة (من عنق الرحم، الإحليل، المستقيم، البلعوم، أو العين) على أوساط زرع انتقائية وغنية (مثل وسط ثاير-مارتين). بعد الحضانة، يتم التعرف على المستعمرات البكتيرية المشتبه بها من خلال خصائصها المظهرية والكيميائية الحيوية والفحص المجهري، مع إجراء اختبار الحساسية للمضادات الحيوية (Antibiogram) للعزلات الإيجابية.